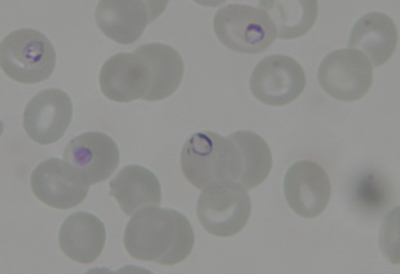
#

45 歳の男性。発熱と倦怠感を主訴に来院した。10 日前にアフリカ中西部から日本に入国した。 7 日前から発熱、倦怠感および食欲不振が出現したため、滞在中のホテルに近い医療機関に入院した。補液、抗菌薬投与などが行われたが、発熱が持続し貧血が進行してきたため、緊急で転院となった。
意識は清明。体温 40.0 ℃。心拍数 100/分、整。血圧 92/60 mmHg。呼吸数 20/分。SpO₂ 98 %(room air)。眼瞼結膜は貧血様で、眼球結膜に黄染を認める。心音と呼吸音とに異常を認めない。腹部は平坦、軟で、右肋骨弓下に肝を 3 cm 触知する。
血液所見:赤血球 327 万、Hb 8.9 g/dL、Ht 24 %、白血球 9,300(桿状核好中球 3 %、分葉核好中球 79 %、単球 4 %、リンパ球 14 %)、血小板 15 万、PT-INR 1.16(基準 0.9~1.1)。血液生化学所見:総蛋白 5.5 g/dL、アルブミン 2.1 g/dL、総ビリルビン 1.9 mg/dL、直接ビリルビン 1.0 mg/dL、AST 56 U/L、ALT 38 U/L、LD 653 U/L(基準 120~245)、ALP 70 U/L(基準 38~113)、γ-GT 46 U/L(基準 8 ~50)、尿素窒素 18 mg/dL、クレアチニン 1.2 mg/dL、血糖 107 mg/dL、Na 135 mEq/L、K 3.6 mEq/L、Cl 104 mEq/L。CRP 21 mg/dL。 末梢血塗抹 May-Giemsa 染色標本を別に示す。
この疾患について正しいのはどれか。2 つ選べ。
a. 防蚊対策が予防に有効である。
b. 原因微生物はウイルスである。
c. 飛沫感染でヒト-ヒト感染する。
d. 重症化すると多臓器不全を起こす。
e. 過去 10 年間に日本国内で感染した例がある。